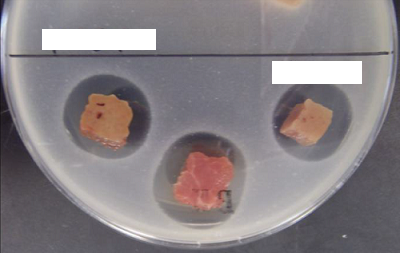
残抗培地

更新日:2025年8月28日
ここから本文です。
内臓や枝肉の検査において異常が認められたものについては,細菌,理化学及び病理検査を行い,異常が明らかとなったものについては「全部廃棄」処分として,食用とならない様に措置をとっています。
また,施設の衛生状況を把握するために,機械器具や枝肉等の拭き取り検査(細菌検査)を定期的に実施しています。
1細菌検査
筋肉や臓器から細菌を分離して,病気の有無を判定しています。
また,拭き取り検査を実施し,施設の衛生指導に役立てています。

豚丹毒菌(顕微鏡写真)

PCR検査の様子

枝肉の拭き取り検査の様子

2理化学検査
血液生化学的検査や筋肉等への残留薬品の分析を行います。
黄疸の枝肉

血液生化学検査の様子

抗菌剤が残留している場合,細菌の発育を抑えて「阻止円」を形成します。
3病理検査
筋肉や臓器の組織学的な検査も行い,異常を判定しています。

4TSE検査
生体検査で異常が認められた場合,必要に応じてTSE検査を実施します(【参照】TSE検査について)。
5調査研究
と畜検査や食鳥検査で確認される家畜疾病等に関する調査研究を行っています。また,これらの成果は学会等で発表するなど,専門知識及び検査技術の向上に努めています。
よくあるご質問
このページに関するお問い合わせ
より良いウェブサイトにするためにみなさまのご意見をお聞かせください